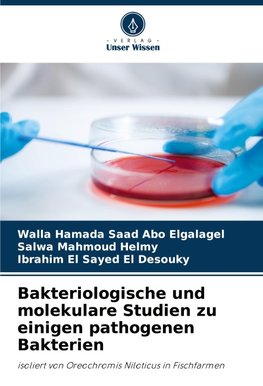
Bakteriologische und molekulare Studien zu einigen pathogenen Bakterien

-
 Nemecký jazyk
Nemecký jazyk
Bakteriologische und molekulare Studien zu einigen pathogenen Bakterien
Autor: Walla Hamada Saad Abo Elgalagel
Na objednávku, dodanie 2-4 týždne
36.99 €
bežná cena: 41.10 €
O knihe
- Vydavateľstvo: Verlag Unser Wissen
- Rok vydania: 2024
- Formát: Paperback
- Rozmer: 220 x 150 mm
- Jazyk: Nemecký jazyk
- ISBN: 9786208365516








 Anglický jazyk
Anglický jazyk 



